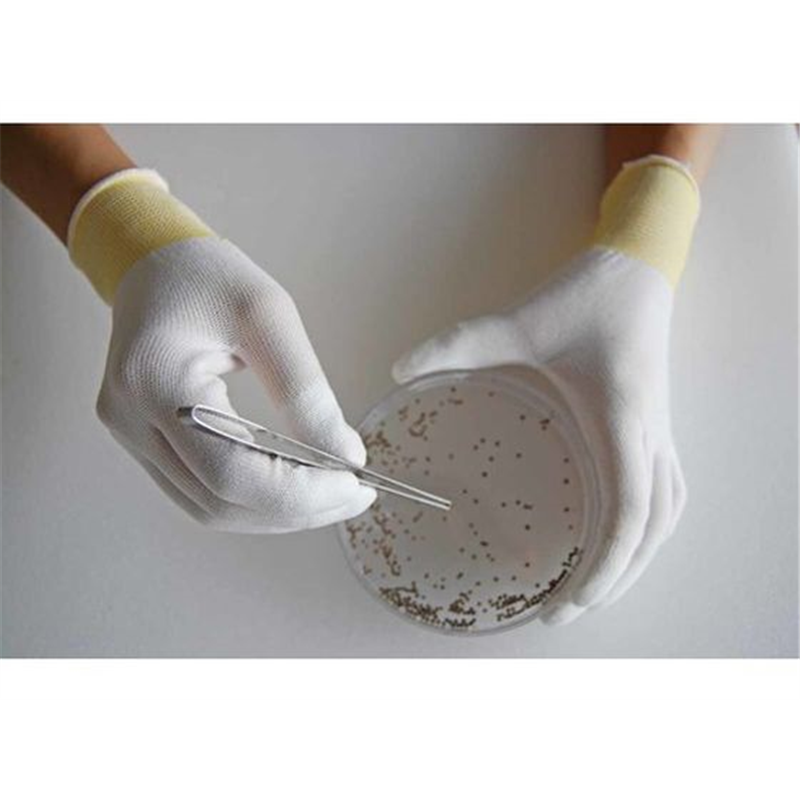

会員様限定 5,400円(税込)以上お買い上げで送料無料!
カテゴリから探す
- 紙袋(3,444)
- 箱(ギフトボックス)(5,605)
- ラッピング用品(34,497)
- ポリ袋(19,670)
- OPP袋(透明袋)(2,220)
- 食品容器・食品包装資材(55,231)
- キッチン用品・厨房用品(243,114)
- 衛生用品・清掃用品(65,736)
- 業務用食品・ギフト(17,781)
- 店舗用品(118,546)
- 文房具・事務用品(164,229)
- パソコン・OA用品(35,182)
- イベント用品(3,965)
- 手芸用品(23,209)
- フラワーアレンジメント資材・フラワーベース(17,683)
- 農業資材・園芸用品(9,610)
- 梱包資材(16,123)
- 物流資材・工場資材(569,667)
- 作業服・ワークウェア・安全靴(145,902)
- 医療・介護用品(56,798)
- 家電・店舗設備(16,645)
- 生活用品・日用雑貨(28,734)
- 研究開発用品・クリーンルーム用品(32,926)
- シモラボ〈特注品〉(2,916)
- シモラボ オフィス(1,884)
ショーワ 簡易包装 トップフィット手袋 10双 B0601 白 S 1袋(ご注文単位1袋)【直送品】
価格:¥2,807(税込)
価格(個単価): ¥2,807(税込)
- 商品コード:
- 2501601167140
- シモジマコード:
- -
- メーカー品番:
- FJ569DB
- 型番:
- B0601-S10P
商品詳細
-
- 商品説明
- 部品の組立・検査。精密機械工業。●指先部分に発泡ウレタン樹脂をコートしており、高いすべり止め効果と優れた通気性を実現しています。
●長繊維を使用した、ホコリ・糸くずの発生しにくい低発じん性手袋です。
●ムレにくいため、指サックの代替としてお使い頂けます。
●コストパフォーマンスに優れた簡易包装タイプです。
●環境に配慮し、包装資材を削減しました。●型番:B0601-S10P
●入数:10双
●色:ホワイト ●サイズ:S ●厚さ(mm):約0.6 ●ゲージ数:13 ●リストカラー:イエロー ●全長(cm):18.5 ●手のひら周り(cm):15.5 ●中指長さ(cm):6.7
●13ゲージ編 ●左右兼用 ●簡易包装
●繊維部:ナイロン、ポリエステル、その他 ●すべり止め部:ポリウレタン(PUR)
●クリーンパックではありません。
※メーカーの都合により、パッケージ・仕様等は予告なく変更になる場合がございます。
-
- メーカー品番
- FJ569DB
-
- 型番
- B0601-S10P
発送元
文具・事務用品関連02

- 本州
- ¥3,980以上で送料無料
¥3,980未満の場合¥880 - 北海道
- ¥3,980以上で送料無料
¥3,980未満の場合¥1,100

沖縄・離島配送不可

返品不可・日曜祝日指定不可
背抜き手袋の人気商品との比較
商品名
価格(税込)
サイズ
発送元
レビュー

ショーワ 簡易包装 トップフィット手袋 10双 B0601 白 S 1袋(ご注文単位1袋)【直送品】
¥2,807
【直送品】文具・事務用品関連02

![エスコ EA354AB-91[M/230mm]手袋(薄手(天然ゴム張り) 1個(ご注文単位1個)【直送品】](https://shimojima.jp/img/goods/Z/4548745219074.jpg)
![エスコ EA354AB-31A[S]手袋(ナイロン・ポリウレタンコート/10双) 1個(ご注文単位1個)【直送品】](https://shimojima.jp/img/goods/Z/4548745282696.jpg)
![エスコ EA354AB-32A[M]手袋(ナイロン・ポリウレタンコート/10双) 1個(ご注文単位1個)【直送品】](https://shimojima.jp/img/goods/Z/4548745282702.jpg)
![エスコ EA354AB-33A[L]手袋(ナイロン・ポリウレタンコート/10双) 1個(ご注文単位1個)【直送品】](https://shimojima.jp/img/goods/Z/4548745282719.jpg)
![エスコ EA354AB-34A[LL]手袋(ナイロン・ポリウレタンコート/10双) 1個(ご注文単位1個)【直送品】](https://shimojima.jp/img/goods/Z/4548745282726.jpg)
![エスコ EA354AB-10[フリー]手袋(ナイロン・天然ゴム張り) 1個(ご注文単位1個)【直送品】](https://shimojima.jp/img/goods/Z/4548745319224.jpg)
![エスコ EA354EE-11[M]手袋(耐切創・滑り止め付/ダイニーマ) 1個(ご注文単位1個)【直送品】](https://shimojima.jp/img/goods/Z/4548745319255.jpg)
![エスコ EA354EE-12[L]手袋(耐切創・滑り止め付/ダイニーマ) 1個(ご注文単位1個)【直送品】](https://shimojima.jp/img/goods/Z/4548745319262.jpg)
![エスコ EA354EE-13[LL]手袋(耐切創・滑り止め付/ダイニーマ) 1個(ご注文単位1個)【直送品】](https://shimojima.jp/img/goods/Z/4548745319279.jpg)
![エスコ EA353BD-77[L]手袋(豚革/あて付) 1個(ご注文単位1個)【直送品】](https://shimojima.jp/img/goods/Z/4548745456707.jpg)
![エスコ EA353BD-78[LL]手袋(豚革/あて付) 1個(ご注文単位1個)【直送品】](https://shimojima.jp/img/goods/Z/4548745459326.jpg)
![エスコ EA354GE-32[L]手袋(耐油・滑り止め/ニトリルゴム・裏付) 1個(ご注文単位1個)【直送品】](https://shimojima.jp/img/goods/Z/4548745727272.jpg)
![エスコ EA354GE-31[M]手袋(耐油・滑り止め/ニトリルゴム・裏付) 1個(ご注文単位1個)【直送品】](https://shimojima.jp/img/goods/Z/4548745727289.jpg)
![エスコ EA354GE-33[LL]手袋(耐油・滑り止め/ニトリルゴム・裏付) 1個(ご注文単位1個)【直送品】](https://shimojima.jp/img/goods/Z/4548745727616.jpg)
![エスコ EA354GJ-26[M]手袋(耐切創/ケブラー・ポリエステル・ニトリルコート) 1個(ご注文単位1個)【直送品】](https://shimojima.jp/img/goods/Z/4548745801972.jpg)
![エスコ EA354GD-11[S]手袋(ポリエステル、綿・天然ゴムコート/緑) 1個(ご注文単位1個)【直送品】](https://shimojima.jp/img/goods/Z/4548745801996.jpg)
![エスコ EA354GD-12[M]手袋(ポリエステル、綿・天然ゴムコート/緑) 1個(ご注文単位1個)【直送品】](https://shimojima.jp/img/goods/Z/4548745802009.jpg)
![エスコ EA354GD-13[L]手袋(ポリエステル、綿・天然ゴムコート/緑) 1個(ご注文単位1個)【直送品】](https://shimojima.jp/img/goods/Z/4548745802016.jpg)
![エスコ EA354GD-14[LL]手袋(ポリエステル、綿・天然ゴムコート/緑) 1個(ご注文単位1個)【直送品】](https://shimojima.jp/img/goods/Z/4548745802023.jpg)
![エスコ EA354GJ-16[M]手袋(耐切創/高強度ポリエチレン・ポリウレタン) 1個(ご注文単位1個)【直送品】](https://shimojima.jp/img/goods/Z/4548745802306.jpg)
![エスコ EA354GJ-17[L]手袋(耐切創/高強度ポリエチレン・ポリウレタン) 1個(ご注文単位1個)【直送品】](https://shimojima.jp/img/goods/Z/4548745802313.jpg)
![エスコ EA354GE-23[LL]手袋(耐油/塩化ビニール・綿PE裏) 1個(ご注文単位1個)【直送品】](https://shimojima.jp/img/goods/Z/4548745802955.jpg)
![エスコ EA354GE-22[L]手袋(耐油/塩化ビニール・綿PE裏) 1個(ご注文単位1個)【直送品】](https://shimojima.jp/img/goods/Z/4548745802979.jpg)
![エスコ EA354GJ-27[L]手袋(耐切創/ケブラー・ポリエステル・ニトリルコート) 1個(ご注文単位1個)【直送品】](https://shimojima.jp/img/goods/Z/4548745804744.jpg)
![エスコ EA354GE-16[M]手袋(耐油/塩化ビニール・綿ポリエステル裏) 1個(ご注文単位1個)【直送品】](https://shimojima.jp/img/goods/Z/4548745805574.jpg)
![エスコ EA354GD-1[S]手袋(薄手・ナイロン、ポリエステル・天然ゴムコート) 1個(ご注文単位1個)【直送品】](https://shimojima.jp/img/goods/Z/4548745805628.jpg)
![エスコ EA354GD-2[M]手袋(薄手・ナイロン、ポリエステル・天然ゴムコート) 1個(ご注文単位1個)【直送品】](https://shimojima.jp/img/goods/Z/4548745805857.jpg)
![エスコ EA354GD-3[L]手袋(薄手・ナイロン、ポリエステル・天然ゴムコート) 1個(ご注文単位1個)【直送品】](https://shimojima.jp/img/goods/Z/4548745805864.jpg)
![エスコ EA354GJ-33[XL]手袋(耐切創/ポリエステル・ステンレス糸ゴムコート) 1個(ご注文単位1個)【直送品】](https://shimojima.jp/img/goods/Z/4548745807226.jpg)






































※ご注文後、在庫がない場合キャンセル等のご連絡をさせていただきます。